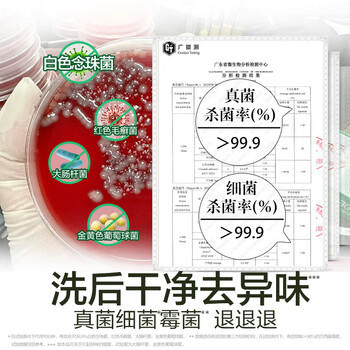
滴露（Dettol）内衣裤消毒除菌液750ml衣物99.9%灭真菌杀菌儿童衣服可配洗衣液 /家庭清洁/纸品 /衣物清洁 /除菌剂 商品图1

滴露(Dettol)内衣裤消毒除菌液750ml衣物99.9%灭真菌杀菌儿童衣服可配洗衣液 /家庭清洁/纸品 /衣物清洁 /除菌剂
¥48.00
| 运费: | 免运费 |
| 库存: | 100000 件 |
商品详情











- 中裕i家-成安店
- 扫描二维码,访问我们的微信店铺